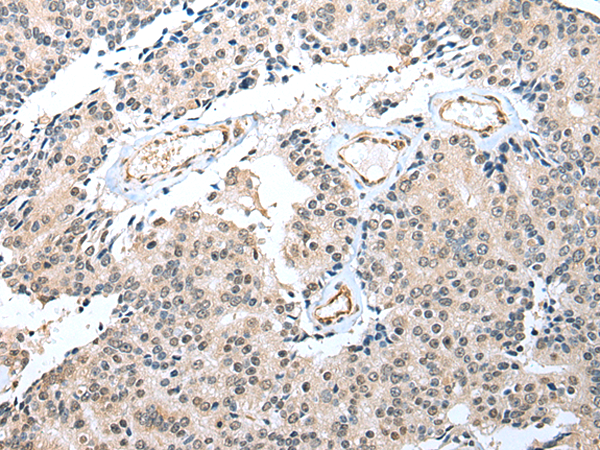

中文名稱:兔抗S100A16多克隆抗體
英文名稱: Anti-S100A16 rabbit polyclonal antibody
別 名: AAG13; S100F; DT1P1A7
相關類別: 一抗
儲 存: 冷凍(-20℃)
宿 主: Rabbit
抗 原: S100A16
反應種屬: Human
標記物: Unconjugate
克隆類型: rabbit polyclonal
技術規(guī)格
|
Background: |
The S-100 protein family consists of a group of calcium-binding proteins that are exclusively expressed in vertebrates and exhibit cell and tissue-specific expression. The expression levels of its members differ in various pathological conditions. The extracellular functions of the S-100 family may include the ability to enhance neurite outgrowth, involvement in inflammation and motility of tumor cells. S-100A16 (S100 calcium binding protein A16), also known as AAG13 (aging-associated gene 13 protein), S100F or DT1P1A7, is a 103 amino acid nuclear and cytoplasmic protein that exists as a homodimer that binds one calcium ion per monomer. A member of the EF-hand superfamily, S-100A16 contains two EF-hand domains and is encoded by a gene that maps to human chromosome 1q21.3. The S-100 protein family consists of a group of calcium-binding proteins that are exclusively expressed in vertebrates and exhibit cell and tissue-specific expression. The expression levels of its members differ in various pathological conditions. The extracellular functions of the S-100 family may include the ability to enhance neurite outgrowth, involvement in inflammation and motility of tumor cells. S-100A16 (S100 calcium binding protein A16), also known as AAG13 (aging-associated gene 13 protein), S100F or DT1P1A7, is a 103 amino acid nuclear and cytoplasmic protein that exists as a homodimer that binds one calcium ion per monomer. A member of the EF-hand superfamily, S-100A16 contains two EF-hand domains and is encoded by a gene that maps to human chromosome 1q21.3. |
|
Applications: |
ELISA, WB, IHC |
|
Name of antibody: |
S100A16 |
|
Immunogen: |
Full length fusion protein |
|
Full name: |
S100 calcium binding protein A16 |
|
Synonyms: |
AAG13; S100F; DT1P1A7 |
|
SwissProt: |
Q96FQ6 |
|
ELISA Recommended dilution: |
5000-10000 |
|
IHC positive control: |
Human prostate cancer and human ovarian cancer |
|
IHC Recommend dilution: |
25-100 |
|
WB Predicted band size: |
12 kDa |
|
WB Positive control: |
MCF-7 cell |
|
WB Recommended dilution: |
500-2000 |
購物車
幫助
021-54845833/15800441009
